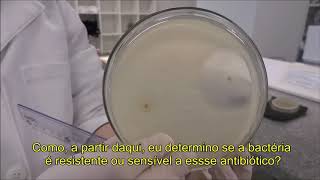

Microbiologia: Teste de Sensibilidade aos Antimicrobianos
4.62k views2 WordsCopy TextShare

Camila de Souza
Video Transcript:
No transcript available.
Related Videos

11:49
Como fazer e interpretar o Antibiograma?
João Marcelo Oliveira
113,982 views

41:43
Urinálise: Exame microscópico do sedimento...
Camila de Souza
21,071 views

27:59
Bacteriologia Básica (parte 1)
Prof. Lidiane Andressa
32,038 views

47:23
MECANISMO DE AÇAO DOS ANTIBIÓTICOS | Acele...
Farmácia Resumida
59,659 views
3:47
Leitura do antibiograma
Gabrielle França Ribeiro
15,713 views

2:18:01
Música Para Estudar e Manter o Foco - Trab...
Cassio Toledo
14,352,620 views

17:48
7 Alimentos que DESTROEM seu FÍGADO (sem v...
Dr. Fernando Lemos - Planeta Intestino
169,878 views

18:37
7 NIGHTTIME HABITS that CAUSE HEART ATTACK...
Cardio DF — Cardiologia e saúde cardiovascular em Brasília (DF)
110,761 views

8:00
Coloração de Gram: Bactérias Gram-positiva...
Bio Aulas - Prof. Matheus Moura
222,760 views

9:53
MECANISMOS DE AÇÃO DOS ANTIMICROBIANOS - P...
Alexandre Funck
37,974 views

45:34
Biomedicina/Farmácia/Análises Clínicas - Q...
Camila de Souza
21,451 views

20:04
MICROBIOLOGIA - VÍRUS | conceito, caracter...
Henac Almeida
96,732 views

13:13
Identificação de Enterobactérias
João Marcelo Oliveira
39,982 views

7:06
ANTIBIÓTICOS: Visão geral | Videoaula | Mi...
Flavonoide
108,219 views

10:00
PSEUDOMONAS - PROF. ALEXANDRE FUNCK
Alexandre Funck
21,583 views

18:11
Tipos de Meios de Cultura Empregados na Mi...
IBAP Cursos
102,794 views

21:21
Trump's Tariff Saga Begins: What Could Go ...
The Daily Show
1,126,195 views

14:29
Hemocultura - O Que é Hemocultura e Como é...
Dra. Keilla Mara de Freitas - Infectologista SP
7,633 views

26:04
13) Ágar CLED Meio de Cultura Urina | Uroc...
IBAP Cursos
11,987 views

20:50
Aula: Microbiologia Médica #1 - Introdução...
Teoria da Medicina
342,539 views